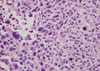

Bone and PThyroid Path (15/16) Flashcards
(79 cards)
understand normal apperance of pituitary gland
pituitary

how does the anterior pituitary stain if it’s growth hormone positive
has a brown immunostain

What does normal posterior pituitary histology look like?
contains pituicytes and axons; secretes antidiuretic hormone (ADH) & oxytocin

What do we see in the anterior pituitary when we perform a reticulin stain?
delinateds small clusters of cells that are held together by extracellular framework.

- 10-15% of all intracranial neoplasms
- Women > men
- 3 rd to 6th decades
Pituitary adenomas
What is the most common hormal secreation of Pituitary adenomas?
Prolactin is most common: (30%)
its a lactotroph/acidophil!!
What is the second most common pituitary adenoma?
Non-secreating (null) cell!
What does a pituitary adenoma look like and how do you resect it?
well circumscribed
via trans-spenoid resection
what is a defining characteristic of pituitary adenoma on HE?
Has dominantly ONE cell type

What do we see with a reticulin stain of a pituitary adenoma?
Destruction of normal pattern of reticulin occurs in adenomas

what does an immunostain look like with pituiatary adenoma?
would expect speckling all over, now with adenoma just have one dominant cell type

- Postpartum ischemic necrosis of pituitary gland
- Pituitary gland enlarges in pregnancy (increased lactotrophs)
– More susceptible to ischemia – Obstetrical hemorrhage or shock – Results in hypopituitarism (anterior, not posterior)
Sheehan syndrome
**of ANTERIOR
- Slight elevation in prolactin level
- Result of lack of inhibitory hypothalamic influence on prolactin
- Caused by a mass/destructive lesion pressing on stalk or hypothalamus-not a prolactinsecreting adenoma
Rathke Cleft Cyst location:
• Sella or suprasellar location
• May produce symptoms or may be asymptomatic (found at autopsy) • Columnar to cuboidal cells with cilia and occasionally mucin, lining a thin walled cyst

Rathkes cleft cyst
what is the devo origin of rathkes cleft cyst
Developmental origin: remnant of Rathke’s cleft pouch
- Benign tumors
- Usually suprasellar, may be within sella, third ventricle or rarely pineal region
Craniopharyngioma
When do craniopharyngiomas usually present?
• Two age peaks – Children (5 to 14yrs): usually adamantinomatous type – Adults (65 to 74 yrs): usually papillary type
What are the presenting symptoms with craniopharnygiomas?
– Visual abnormalities (chiasm)
– Hypopituitarism
– Misplaced odontogenic epithelium
– Vestigal remnants of Rathke’s pouch
possible histogenesis of craniopharnygiomas
– Cysts filled with dark brown fluid (motor oil) and cholesterol crystals – Basally palisading squamous epithelium
– Abundant keratin
– Local invasion of brain with chronic inflammation
Adamantinomatous type

Your 10 yr old pt recently has a tumor biopsied from the suprasellar region. The tumor has abundant keritin and basaly palisading sq epithelium. Dx?

Craniopharnygioma adamantinomatous type
Describe papillary type craniopharnygioma and who do we see it in?
Papillary type
– Papillary architecture
– No keratin formation
Why is recurrence common in craniopharngiomas?
Recurrence occurs due to difficulty in completely resecting